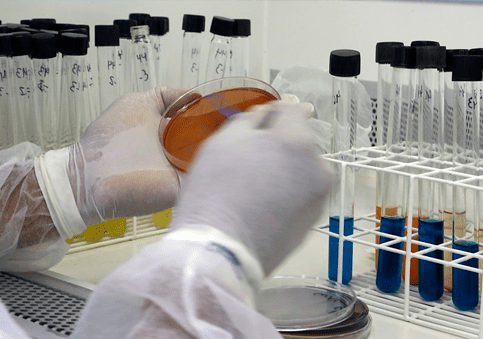

A variação de preços cobrados por exames laboratoriais em Campo Grande, só reforça a importância de pesquisar antes de comprar ou contratar um serviço. Entre alguns dos 110 tipos de exames diferentes pesquisados pelas equipes do Procon/MS, a variação chegou a absurdos 1.532,50%.
Todos os exames tiveram variação de preço superior a 100%. A maior variação foi de 1.532,50% no exame para detecção de CK MB, específico para detecção de enzima no músculo do coração, capaz de diagnosticar ataque cardíaco. O maior valor cobrado foi R$ 163,25 e o menor valor encontrado foi de R$ 10,00.
A menor variação foi de 106,50% no exame Beta Qualitativo, sendo que o maior valor encontrado de R$ 451,30 e o menor valor (R$ 20,00).
Entre os exames avaliados estão o de hematologia, exames de bioquímica básica/ nível básica I, exames nível II, exames nível III, exames hormonais comuns e exames de sorologia/imunologia.
A pesquisa completa com todos os tipos de exames pesquisados, os laboratórios onde foram verificados e a variação de cada um deles pode ser conferida no site do Procon/MS www.procon.ms.gov.br.
Subcom